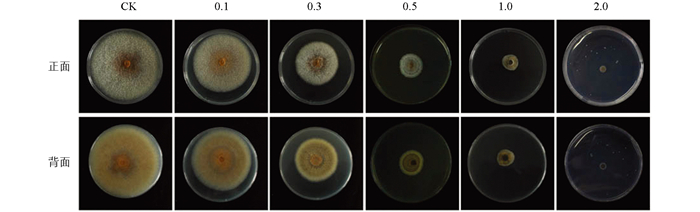
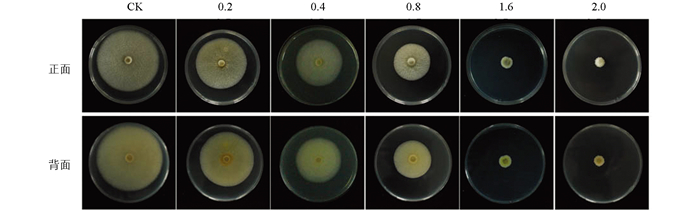

-
开放科学(资源服务)标识码(OSID):

-
云纹叶枯病(Brown Blight Disease)是由炭疽属真菌引起的一类极具破坏性的茶树叶部病害[1-4]。病害初期茶树叶片常出现水渍状斑点,发病后期病斑逐渐扩大,严重时造成叶片大面积枯死脱落,影响茶树的正常生长发育,降低了茶叶的产量及品质。随着分子生物学的发展,以形态学特征为基础,结合多基因系统发育分析和致病性检测现已鉴定出至少16种茶树炭疽菌,其中C. gloeosporioides和C. camelliae被认为是茶树上主要的优势致病菌[3-5],因此对这两种茶树主要炭疽菌种的研究对于茶树云纹叶枯病的防治具有重要意义。
苯并咪唑类杀菌剂作为广谱性杀菌剂,使用范围广,但该类杀菌剂的作用位点单一,长期连续使用易导致病原菌产生抗性。甲基硫菌灵又名甲基托布津,是一种内吸性强、高效低毒、安全广谱的苯并咪唑类杀菌剂,在粮食[6]、果蔬[7-8]、药材[9]中都有广泛的应用,但相关的系统性研究报道较少。目前,茶树病害及其防治主要以化学农药防治为主,致使农药使用量过多,农药残留问题突出。甲基硫菌灵虽是茶树病害的常见防治药剂,但对茶树病害中不同炭疽菌种的应用效果及其差异性却一直缺乏系统的数据研究,使得该药剂在防治茶树云纹叶枯病时缺乏精准性。C. gloeosporioides和C. camelliae是引起茶树云纹叶枯病的主要病原菌种,本文研究了甲基硫菌灵对两种主要优势炭疽菌种的抑菌活性,并通过菌落生长情况、生物学活性分析等初步明确了甲基硫菌灵对炭疽菌的抑菌作用机制,旨在为茶树云纹叶枯病的防治提供理论依据。
HTML
-
所用的菌株为2016-2019年在重庆各茶叶种植区采集的茶树感病样本,经过形态学特征、多基因遗传进化分析和致病性检测鉴定为胶孢炭疽菌(C. gloeosporioides)及山茶炭疽菌(C. camelliae)[4-5]。甲基硫菌灵购买于芜湖贝达化工有限公司,纯度为98%。
-
马铃薯去皮后清洗干净并切成小块,称取200 g,放入锅中,加入1 L无菌蒸馏水,加热直至土豆松软。取洁净纱布8层进行过滤,弃置滤渣,用无菌蒸馏水将滤液补充至1 L,重新倒入锅中,加入20 g琼脂粉(POB培养液不加)及20 g葡萄糖,加热搅拌使其充分溶解,定量分装,高压灭菌锅内灭菌20 min,备用。
母液配置:精准称取甲基硫菌灵粉末500 mg置于100 mL的烧杯中,加入适量的二甲基亚砜(DMSO)溶解,转移至50 mL容量瓶中,用ddH2O将烧杯洗涤2~3次后,将容量瓶用ddH2O定容到刻度线处,甲基硫菌灵母液浓度10 mg/mL,过滤除菌后备用。
带药培养基制备:将保存备用的灭菌PDA,用微波炉加热至完全融化,冷却至50 ℃左右,取定量甲基硫菌灵母液加入PDA中,使其分别配制成不同浓度的培养基。经预实验筛选设置C. gloeosporioides浓度梯度为0.1、0.3、0.5、1.0、2.0 μg/mL;C. camelliae浓度梯度为0.2、0.4、0.8、1.6、2.0 μg/mL。
-
将培养5 d的病原菌种用打孔器打成菌块(d=7 mm)后,接种至带药培养基上,放置于(25±2) ℃生化培养箱中培养,从第2 d开始,每天同一时间用十字交叉法测量菌落直径,待第5 d时用数码相机拍摄记录菌落大小,并利用显微镜观察菌丝在不同甲基硫菌灵浓度下的形态特征,每次实验共设置2个平行,重复3次。
-
采用SPSS 20.0软件计算抑菌率和EC50,Adobe Photoshop CS5处理菌丝和分生孢子图片。
菌丝生长抑菌率(R抑菌)计算公式:
式中:D对照为对照菌落直径;D处理为处理菌落直径;D菌饼为菌饼直径。
-
取灭菌后的PDA培养基,配制EC50浓度带药培养基,对照组中加入等量无菌ddH2O。将培养5 d的菌种打成菌块后,接种至事先配置好的带药培养基上,放置于(25±2) ℃生化培养箱中培养5~10 d,将菌丝制片于40倍成像显微镜(Olympus,U-TV0.5XC-3)下观察菌丝以及孢子的生长情况。
-
使用PDA培养基培养菌种5 d,用打孔器将菌落打成菌块后,取4个菌块接入PDB培养液中,置于150 r/min、(25±2) ℃的摇床上培养5 d。使用电导仪测量培养液的电导率,将培养液加热到沸腾,冷却后再测量1次,记录下前后电导率数据。
式中:R电导为相对电导率,R原液为培养原液电导率;R煮沸后为煮沸后培养液电导率。
-
参考Shao等[10]的方法对待测菌进行培养,使用硫代巴比妥酸法[11]测定MDA含量。将培养5 d后的菌种打孔,取菌饼接种于PDB培养液中,将培养液置于160 r/min、26 ℃的摇床上培养2 d。在PDB培养基中加入甲基硫菌灵,使其终浓度为2 μg/mL,空白组加入等量DMSO。在培养0、12、24 h后取0.5 mL待测液,加入0.5 mL硫代巴比妥酸(0.67%),混合热30 min后,置于冷水中冷却,在6 687 r/min下离心10 min。用5%三氯乙酸溶液调零,上清液在450 nm、532 nm和600 nm处测定吸光值。按公式计算丙二醛浓度(C):
式中:A450、A532、A600分别代表450 nm、532 nm、600 nm波长下的吸光度值。进一步算出其在植物组织中的含量:
式中:W为丙二醛含量(μmol/mL-1);C为丙二醛浓度;V为丙二醛提取液体积。
1.1. 病原菌来源
1.2. 培养基制备
1.3. 病原菌接种培养
1.4. 抑菌率计算
1.5. 分生孢子与菌丝形态学观察
1.6. 相对电导率测定
1.7. 丙二醛(MDA)含量测定
-
图 1显示,经不同浓度的甲基硫菌灵处理后,C. gloeosporioides的菌落生长受到抑制,且随甲基硫菌灵浓度的增加,抑菌效果逐渐增强。当浓度为0.5 μg/mL时,接种5 d后,与对照相比,甲基硫菌灵对C. gloeosporioides的抑菌效果明显,菌落直径从7.50 cm减少至3.005 cm,抑菌率达到66.10%,之后随着药剂浓度的增大,抑菌效果变化幅度变小;当浓度达到2.0 μg/mL时,C. gloeosporioides菌落几乎不生长,抑菌率达到94.61%。整体来讲,甲基硫菌灵处理后,C. gloeosporioides菌落的形态及颜色变化不大,菌丝灰白色,分生孢子呈橙黄色,但随着浓度增大,达到0.5 μg/mL时,菌丝成簇生长,分生孢子数量极大减少,表明甲基硫菌灵对C. gloeosporioides的菌丝及分生孢子的生长起到了明显的抑制作用。
-
图 2显示,甲基硫菌灵处理后,C. camelliae菌落生长受到明显的抑制,抑菌效果随着浓度的增加而明显增大。0.2 μg/mL时菌落直径为6.30 cm,抑菌率为23.74%;当浓度增加到1.6 μg/mL时,菌落直径减至1.65 cm,抑菌率达86.99%。总体上来说,0.2~0.8 μg/mL浓度内抑菌率变化小,1.6 μg/mL与2.0 μg/mL两个浓度对菌种的抑制作用比较接近,说明随药剂浓度的逐步增大,病原菌的敏感性有所降低。C. camelliae菌落颜色以及形态在甲基硫菌灵处理后无明显变化,但随浓度的增加菌丝呈簇状生长,分生孢子数量明显减少。
-
甲基硫菌灵处理后,两种炭疽菌C. gloeosporioides(图 3a)和C. camelliae(图 3b)的EC50分别为0.349、0.647 μg/mL,表明甲基硫菌灵对C. gloeosporioides抑菌活性更高,在较低的浓度下能达到更好的抑制效果,且随着药剂浓度的增加,抑菌率逐渐增大。浓度为1.0 μg/mL时,甲基硫菌灵对C. gloeosporioides的抑菌率可达84.56%,2.0 μg/mL时可达到94.61%。相比之下,甲基硫菌灵对C. camelliae的抑菌率在浓度1.6 μg/mL时为86.99%,2.0 μg/mL时为89.04%。综上所述,在较低的浓度下,甲基硫菌灵对C. gloeosporioides具有更好的防治效果。
-
图 4显示,正常生长下两种炭疽菌的菌丝整体形态均匀且较直,甲基硫菌灵(EC50)处理后,两种菌的菌丝形态均呈现出不同程度的局部增粗,大部分菌丝的顶端产生不规则膨大,菌丝整体生长也呈现畸形,表明在甲基硫菌灵的作用下,菌丝顶端分生组织的生长受到抑制,使得菌丝的生长发育变得缓慢甚至停止。
-
图 5显示,正常生长的孢子生长发育良好,形态呈较为规则的长椭圆形,大小较为一致。C. gloeosporioides的分生孢子呈长圆柱形,孢子整体透明,内部无隔膜,两端钝圆,大小为12.60~18.50 μm(长)× 4.30~7.50 μm(宽);C. camelliae的分生孢子呈圆柱状,末端呈钝形或向底部狭窄,整体透明,内部无隔膜,大小为11.7~18.9 μm(长)×4.1~7.61 μm(宽)。甲基硫菌灵(EC50)处理后,分生孢子整体数量呈减少趋势,部分分生孢子生长明显受到抑制,在形态上表现为局部不规则膨大。
-
细胞膜透性以细胞相对电导率的大小表示[12]。结果表明,两种炭疽菌在甲基硫菌灵的处理下,菌丝相对电导率随着甲基硫菌灵浓度的增加整体呈现上升趋势,相比之下,C. gloeosporioides电导率相对稳定地升高(图 6a),C. camelliae变化幅度波动较大(图 6b),表明在甲基硫菌灵作用下,2种炭疽菌的细胞膜均被损伤,且随药剂浓度的增大损伤程度加剧。
-
丙二醛(MDA)是细胞在逆境胁迫下脂质过氧化作用的主要产物之一,由于MDA本身具有较强的毒性,可以在生物代谢中对细胞膜结构造成损伤,从而破坏细胞膜,影响细胞的功能[13]。在甲基硫菌灵处理后24 h内,两种炭疽菌的MDA含量均在12 h内呈现出急剧上升、而后又急剧下降的趋势,而对照组(CK)变化不大(图 7),但C. gloeosporioides的上升幅度明显大于C. camelliae,说明甲基硫菌灵对C. gloeosporioides的组织过氧化损伤程度更大,尤其是在12 h后。
2.1. 甲基硫菌灵对C. gloeosporioides的抑菌活性分析
2.2. 甲基硫菌灵对C. camelliae的抑菌活性分析
2.3. 抑菌活性比较
2.4. 甲基硫菌灵对炭疽菌菌丝生长的影响
2.5. 甲基硫菌灵对炭疽菌分生孢子的影响
2.6. 甲基硫菌灵对炭疽菌细胞膜透性的影响
2.7. 甲基硫菌灵对炭疽菌丙二醛(MDA)的影响
-
云纹叶枯病是茶树主要叶部病害之一,长期以来病害防治难度大且容易反复感染。近年来由于分子鉴定技术的发展,引起茶树云纹叶枯病的病原菌种类越来越多地被鉴定并报道,且不同病原菌种的生物学特性等差异较大,致使不同地区或同一地区不同菌种的病害防治效果差异较大。C. gloeosporioides和C. camelliae被认为是引起茶树云纹叶枯病的两种主要病原菌种,严重影响着茶叶的产量和品质[3-5]。甲基硫菌灵是目前在多种农业经济作物中广泛应用的农药[6-9],在茶树病害防治中也一直被广泛应用,但甲基硫菌灵对茶树病害的防治效果一直缺乏系统的数据研究,尤其是对同一病原菌的不同菌种的作用效应还未见有系统报道。本研究结果证实了甲基硫菌灵对茶树主要优势炭疽菌种均具有较高的抑菌活性,且对不同炭疽菌种的抑菌效果存在明显差异,研究结果对茶树炭疽菌的高效、针对性防治具有重要的指导意义。
通过进一步显微镜检和生物活性检测发现,甲基硫菌灵对不同炭疽菌种具有相似的抑菌机制,均是通过抑制菌丝和分生孢子的生长,造成茶炭疽菌的组织过氧化损伤加剧,从而达到病害防治的效果。本研究证实了甲基硫菌灵对炭疽菌的两个优势菌种均具有较好的抑制效果,但有研究报道认为甲基硫菌灵具有不稳定性,会先转化为多菌灵[14-16],再通过植物叶片与根吸收进入植物体内,进而干扰植物有丝分裂纺锤体的形成。甲基硫菌灵属于苯并咪唑类杀菌剂,研究表明,植物病原菌对苯并咪唑类药剂易产生抗药性,而产生抗药性的主要原因是病原菌β-微管蛋白基因的198或200位的氨基酸发生突变[17-20],同时苯并咪唑类药剂之间易产生交互抗性[21-22],进而限制了同类杀菌剂的复配使用。目前,多菌灵在茶树上的农药残留问题已相对突出,且随着病原菌抗药性的增强,导致防治效果下降,因此,进一步开展甲基硫菌灵对茶树生长发育以及农药残留等方面的研究,将对甲基硫菌灵在茶树上的高效、安全应用起到指导作用。
-
本研究以两种茶树优势炭疽菌种C. gloeosporioides和C. camelliae为研究对象,证实了甲基硫菌灵对两种不同茶炭疽菌均具有较好的抑菌活性,但对不同炭疽菌种的抑菌效果存在明显差异。通过对处理后的菌丝和分生孢子的生长形态进行显微镜检,发现甲基硫菌灵处理后两种炭疽菌的菌丝数量均明显减少,且伴有不规则膨大现象,分枝多且短,分生孢子形态也出现了不同程度的畸形;相对电导率和MDA含量检测分析表明,甲基硫菌灵作用下两种炭疽菌的细胞膜结构均遭到不同程度的破坏,细胞膜的透性增大,但C. gloeosporioides对甲基硫菌灵的敏感性明显高于C. camelliae。研究结果为茶树炭疽菌的高效、针对性防治提供了数据参考。

DownLoad:
DownLoad: